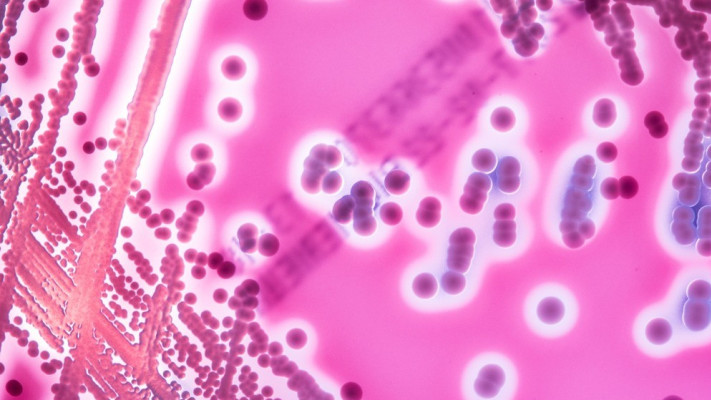
סטרפטוקוק. עלול לפלוש לאיברים פנימיים

סטרפטוקוק A הוא חיידק המצוי בדרך כלל בלוע ובאף של בני אדם בריאים, ולעיתים אף על העור, מבלי לגרום לתסמינים. אולם כשהמערכת החיסונית נחלשת או החיידק חודר לרקמות עמוקות יותר, הוא עלול לגרום למחלות חמורות. ברוב המקרים מדובר בדלקת גרון קלאסית או בזיהום שטחי בעור, אולם לעיתים נדירות יותר עלול להתפתח זיהום פולשני, מצב שבו החיידק חודר לדם, לרקמות רכות או לאיברים פנימיים.
במקרים אלה מדובר בזיהום מסוכן במיוחד, שעלול לגרום לדלקת קרום הלב, דלקת ריאות חריפה, אלח דם ואף לנמק של רקמות. שיעור התמותה ממחלות פולשניות הנגרמות מהחיידק עלול להגיע ל־15-20 אחוזים, בעיקר בקרב קשישים, תינוקות ואנשים עם מערכת חיסונית מוחלשת.
לדברי מומחים למחלות זיהומיות, הסיבה לעלייה החדה השנה אינה ברורה לחלוטין, אך ייתכן שהיא קשורה לשילוב של כמה גורמים: לאחר תקופת הקורונה שבה ננקטו צעדי מניעה נרחבים כמו מסכות והגבלות התקהלות, נחשפה האוכלוסייה מחדש למגוון רחב של מזהמים. בנוסף, שינויים עונתיים ומזג אוויר חמים מהרגיל יכולים לתרום להתפשטות מהירה יותר של החיידק בבתי ספר, גנים ומקומות עבודה סגורים.
חלק מהמומחים מעריכים כי קיימת גם אפשרות לשינוי גנטי מסוים בזני הסטרפטוקוק הפעילים בישראל, מה שהופך אותם לאלימים יותר ולבעלי יכולת הדבקה גבוהה. עם זאת, נדרשות בדיקות מעבדה נרחבות כדי לוודא זאת. משרד הבריאות ציין כי מתבצעת בימים אלה בדיקה אפידמיולוגית מקיפה כדי לזהות דפוסים גאוגרפיים ולבדוק אם מדובר בזנים חדשים של החיידק.
לא כל דלקת גרון דורשת טיפול אנטיביוטי, וכי במקרים רבים הגורם הוא נגיפי. עם זאת, מומלץ לפנות לרופא בכל מקרה של חום גבוה ממושך או כאב גרון חזק במיוחד, במיוחד אם מדובר בילדים צעירים או באנשים עם מחלות רקע. לדברי גורמים רפואיים, מומלץ לשים לב גם לסימנים מוקדמים של סיבוכים עוריים כמו פצעים מזוהמים, אדמומיות נרחבת או כאבים עזים באזור מקומי ולפנות מיידית לטיפול רפואי אם מופיעים תסמינים אלה.

